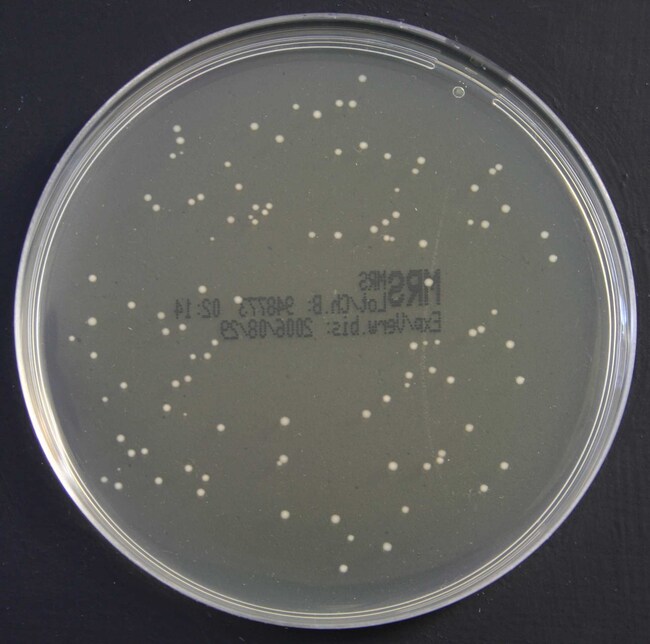
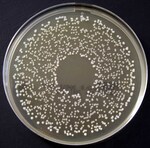
Oxoid MRS Agar

Search
Oxoid MRS Agar
| 货号 | 颜色 | 原料来源 | 容纳重量 | 有效期 |
|---|---|---|---|---|
| PO5047A | 乳白色,透明 | 德国 | 17g ± 5% | 26 Weeks |
Cultivate, isolate and enumerate lactic acid bacteria with Thermo Scientific™ Oxoid™ MRS Agar. The formulation was developed by de Man, Rogosa and Sharpe1 to replace a variable product (tomato juice) and, at the same time, to provide a medium which would support good growth of lactobacilli in general, even those strains which showed poor growth in existing media. It gives more profuse growth of all strains of lactobacilli, especially the difficult and slow-growing strains of Lactobacillus brevis and Lactobacillus fermenti1,2.
Use M.R.S. Agar for enumeration and isolation of lactic acid bacteria from food samples. M.R.S. Agar encourages the growth of the lactic acid bacteria, which includes species of the following genera: Lactobacillus, Streptococcus, Pediococcus, and Leuconostoc.
- Superior performance over the tomato juice medium of Briggs1 and the meat extract tomato juice medium of de Man
- Ready-to-use convenience of prepared media
The MRS formulation was developed by de Man, Rogosa and Sharpe1 to replace a variable component (tomato juice) and, at the same time, provide a medium which would support good growth of lactobacilli in general, even those strains which showed poor growth in existing media. M.R.S. Agar is superior to the tomato juice medium of Briggs2 and the meat extract tomato juice medium of de Man. It gives more profuse growth of all strains of lactobacilli, especially the difficult and slow growing strains of Lactobacillus brevis and Lactobacillus fermenti.
The `lactic acid bacteria’ are Gram-positive, catalase and oxidase negative and are fastidious in their nutritional requirements. Growth is enhanced considerably by microaerobic conditions. Generally the `lactic acid bacteria’ show delayed growth and smaller colony size than other microorganisms. They may be overgrown in non-selective media, especially if incubation is required for 2-4 days.
Not all products are available for sale in all territories. Please inquire.
Remel™ and Oxoid™ products are now part of the Thermo Scientific brand.